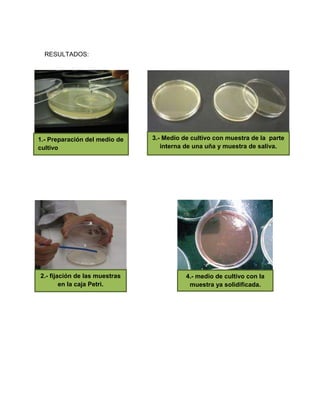
RESULTADOS:
3.- Medio de cultivo con muestra de la parte
interna de una uña y muestra de saliva.
1.- Preparación del medio de
cultivo
2.- fijación de las muestras
en la caja Petri.
4.- medio de cultivo con la
muestra ya solidificada.

Este documento describe los medios de cultivo y su historia. Explica que un medio de cultivo es un material de crecimiento para microorganismos. En 1881, Koch desarrolló un método para cultivar bacterias en gelatina sólida y placa para obtener cultivos puros. En 1882, Hesse introdujo el agar como solidificante de cultivos. En 1887, Petri comenzó a usar placas de vidrio planas ahora llamadas placas de Petri para cultivar muestras. El documento también presenta un procedimiento para preparar un medio de cultivo de agar